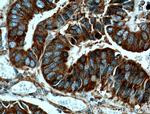
RACGAP1 Antibody in Immunohistochemistry (Paraffin) (IHC (P))

Search
Proteintech
RACGAP1 Monoclonal Antibody (6E10A2)
{{$productOrderCtrl.translations['antibody.pdp.commerceCard.promotion.promotions']}}
{{$productOrderCtrl.translations['antibody.pdp.commerceCard.promotion.viewpromo']}}
{{$productOrderCtrl.translations['antibody.pdp.commerceCard.promotion.promocode']}}: {{promo.promoCode}} {{promo.promoTitle}} {{promo.promoDescription}}. {{$productOrderCtrl.translations['antibody.pdp.commerceCard.promotion.learnmore']}}
产品信息
66056-1-IG
种属反应
宿主/亚型
分类
类型
克隆号
抗原
偶联物
形式
浓度
规格
纯化类型
保存液
内含物
保存条件
运输条件
产品详细信息
Immunogen sequence: PCIPTLIGT PVKIGEGMLA DFVSQTSPMI PSIVVHCVNE IEQRGLTETG LYRISGCDRT VKELKEKFLR VKTVPLLSKV DDIHAICSLL KDFLRNLKEP LLTFRLNRAF MEAAEITDED NSIAAMYQAV GELPQANRDT LAFLMIHLQR VAQSPHTKMD VANLAKVFGP TIVAHAVPNP DPVTMLQDIK RQPKVVERLL SLPLEYWSQF MMVEQENIDP LHVIENSNAF STPQTPDIKV SLLGPVTTPE HQLLKTPSSS SLSQRVRSTL TKNTPRFGSK SKSATNLGRQ GNFFASPMLK (334-632 aa encoded by BC032754)
靶标信息
RAC, a small GTPase in the ras family, regulates the formation of membrane ruffles, lamellipodia and filopodia. It is involved in cytoskeletal actin organization and transformation. The p21 activated kinases (PAKs) are direct targets of active Rac and Cdc42 which can induce the assembly of polarized cytoskeletal structures when expressed in fibroblasts. RAC1 and RAC2 are also essential components of NADPH oxidase, the enzyme responsible for generating free radicals.
仅用于科研。不用于诊断过程。未经明确授权不得转售。
篇参考文献 (0)
生物信息学
蛋白别名: AKT; CYK4; GAP; ID; Male germ cell RacGap; MGC99656; MgcRacGAP; PKB; PKB-ALPHA; PRKBA; protein CYK4 homolg; Protein CYK4 homolog; RAC; Rac GTPase-activating protein 1; RAC-ALPHA; RACGAP1; unnamed protein product
基因别名: AI227039; AI327394; Band25; CDAN3B; CYK4; gtl11; GTPase; HsCYK-4; ID-GAP; KIAA1478; MGCRACGAP; mKIAA1478; RACGAP1; RCGAP1
UniProt ID: (Human) Q9H0H5, (Mouse) Q9WVM1
Entrez Gene ID: (Human) 29127, (Mouse) 26934, (Rat) 315298